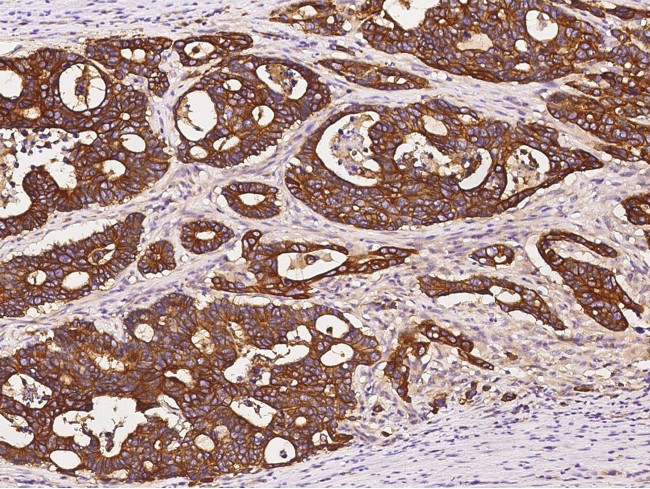
APRIL Antibody in Immunohistochemistry (Paraffin) (IHC (P))

Search
Invitrogen
APRIL Polyclonal Antibody
{{$productOrderCtrl.translations['antibody.pdp.commerceCard.promotion.promotions']}}
{{$productOrderCtrl.translations['antibody.pdp.commerceCard.promotion.viewpromo']}}
{{$productOrderCtrl.translations['antibody.pdp.commerceCard.promotion.promocode']}}: {{promo.promoCode}} {{promo.promoTitle}} {{promo.promoDescription}}. {{$productOrderCtrl.translations['antibody.pdp.commerceCard.promotion.learnmore']}}
产品信息
PA5-81085
宿主/亚型
分类
类型
抗原
偶联物
形式
浓度
保存条件
运输条件
RRID
产品详细信息
This product is preservative free. It is recommended to add sodium azide to avoid contamination (final concentration 0.05%-0.1%).
This antibody has specificity for Human APRIL/cd256.
靶标信息
Members in the TNF superfamily regulate immune responses and induce apoptosis. A novel member in the TNF family was recently identified by several groups and designated APRIL (for A PRoliferation-Inducing Ligand), TALL2 (for TNF and ApoL-related Leukocyte-expressed Ligand 2), and TRDL 1a (for TNF related death ligand 1a) in human and mouse. Two receptors for APRIL were recently identified and designated TACI and BCMA. APRIL stimulates B and T cell proliferation, triggers humoral immune responses, activates NF-kB, and induces cell death. APRIL and its close relative of BlyS and their receptors BCMA and TACI are involved in diseases of autoimmunity and cancer.
仅用于科研。不用于诊断过程。未经明确授权不得转售。